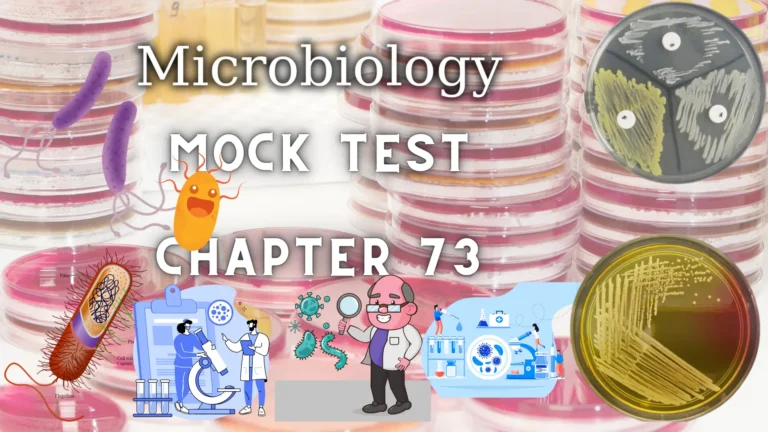

Chapter 88 (Questions No 4351 – 4400) of our Mock Test series is specifically designed for lab technicians and technologists. This chapter delivers a comprehensive review of key topics such as anatomy, physiology, microbiology, chemistry, and hematology. It’s an invaluable resource for both self-assessment and exam preparation, helping you to strengthen your understanding, enhance your test-taking skills, and build the confidence necessary to excel in your exams.

4351 to 4400 MCQs Mock Test for Lab Technician and Technologist Exam Preparation
If You like then share this to your friends and other social media.
If You have any question and suggestions then please Contact us Here
Chapter 88 (Questions No 4351 – 4400) of our Mock Test series is meticulously crafted to cater to the needs of lab technicians and technologists. This chapter delves into essential topics that form the bedrock of clinical laboratory sciences. Whether you’re preparing for certification exams or seeking to enhance your practical knowledge, this section offers an extensive array of questions that test your understanding of critical subjects. The thoughtfully designed questions challenge you to think critically and apply your knowledge in real-world scenarios, ensuring a well-rounded preparation.
Anatomy and physiology are foundational subjects covered extensively in this chapter. These areas are crucial for understanding the human body’s structure and function, providing a vital basis for diagnosing and understanding various medical conditions. By exploring these topics through our mock test questions, you can reinforce your grasp of complex systems and processes within the body. This not only aids in exam preparation but also deepens your clinical comprehension, an invaluable skill for any healthcare professional.
Microbiology and chemistry form another significant part of this chapter. Understanding the microscopic organisms that cause diseases and the chemical reactions that occur in the body are fundamental to clinical laboratory sciences. The questions in this section are designed to test your knowledge of pathogenic microorganisms, laboratory techniques for identifying them, and the chemical principles relevant to diagnostics. These topics are particularly important for laboratory technologists who play a critical role in identifying and managing infections and other conditions.
Hematology, the study of blood and its disorders, is another focal point of Chapter 88. This subject is vital for diagnosing a range of diseases, from anemia to leukemia. The mock test questions in this area cover various aspects, including blood cell morphology, hemostasis, and hematologic diseases. By tackling these questions, you can refine your diagnostic skills and prepare for practical challenges in the clinical setting. Overall, this chapter serves as a comprehensive resource for building a strong foundation in clinical laboratory sciences, offering a thorough review and practice opportunity for those aspiring to excel in their careers.